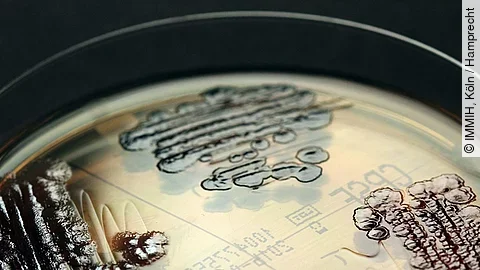
Multiresistente Keime Multiresistente Keime

In Sachsen-Anhalt haben sich im vergangenen Jahr laut einer Statistik deutlich weniger Menschen mit dem Krankenhauskeim MRSA infiziert. Es seien 58 Fälle erfasst worden nach 102 im Jahr 2019, teilte das Landesamt für Verbraucherschutz in Halle auf Nachfrage mit. 2015 hatte es laut Statistik 185 Infektionen gegeben. Der Trend ist seit mehreren Jahren rückläufig. In diesem Jahr seien bis Anfang Mai 14 Fälle erfasst worden. Ein Mensch starb daran. Im vergangenen Jahr waren zwei Infizierte gestorben, 2019 fünf.
MRSA steht für Methicillin-resistenter Staphylococcus aureus. Die Bakterien kommen auf der Haut und in den Schleimhäuten vieler gesunder Menschen vor. Erst wenn die Bakterien über Wunden oder durch die Schleimhäute in den Körper gelangen, kann eine Infektion ausbrechen. Da MRSA gegen viele Antibiotika unempfindlich sind, kann eine Erkrankung einen schweren Verlauf - bis zum Tod - nehmen.
MRSA ist bei weitem nicht der einzige Krankenhauskeim. 146 Fälle und 26 Verstorbene wurden 2020 etwa für Clostridioides-difficile-Erkrankungen (CDI) registriert. 2019 waren es laut dem Landesamt für Verbraucherschutz 134 Fälle und 22 Gestorbene.
Das Robert Koch-Institut hat festgestellt, dass die Corona-Pandemie Auswirkungen auf verschiedene meldepflichtige Infektionskrankheiten hat - von der Grippe bis zu Krankenhauskeimen. Dabei gebe es mehrere Faktoren: So nähmen die Menschen weniger medizinische Leistungen in Anspruch, die Zahl der Patienten in den Krankenhäusern sei gesunken. Zudem werde mehr getestet und die Hygienemaßnahmen seien verstärkt worden.

Derzeit sind noch keine Kommentare vorhanden. Schreiben Sie den ersten Kommentar!
Jetzt einloggen